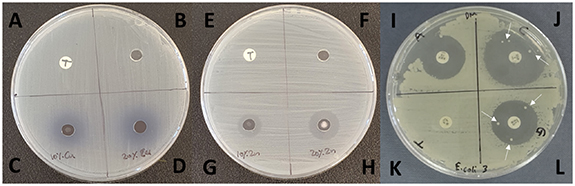
Figure 4.

Abstract
With the advent of nanotechnology, there has been an extensive interest in the antimicrobial potential of metals. The rapid and widespread development of antimicrobial-resistant and multidrug-resistant bacteria has prompted recent research into developing novel or alternative antimicrobial agents. In this study, the antimicrobial efficacy of metallic copper, cobalt, silver and zinc nanoparticles was assessed against Escherichia coli (NCTC 10538), S. aureus (ATCC 6538) along with three clinical isolates of Staphylococcus epidermidis (A37, A57 and A91) and three clinical isolates of E. coli (Strains 1, 2 and 3) recovered from bone marrow transplant patients and patients with cystitis respectively. Antimicrobial sensitivity assays, including agar diffusion and broth macro-dilution to determine minimum inhibitory and bactericidal concentrations (MIC/MBC) and time-kill/synergy assays, were used to assess the antimicrobial efficacy of the agents. The panel of test microorganisms, including antibiotic-resistant strains, demonstrated a broad range of sensitivity to the metals investigated. MICs of the type culture strains were in the range of 0.625–5.0 mg ml−1. While copper and cobalt exhibited no difference in sensitivity between Gram-positive and Gram-negative microorganisms, silver and zinc showed strain specificity. A significant decrease (p < 0.001) in the bacterial density of E. coli and S. aureus was demonstrated by silver, copper and zinc in as little as two hours. Furthermore, combining metal nanoparticles reduced the time required to achieve a complete kill.
Export citation and abstract BibTeX RIS

Original content from this work may be used under the terms of the Creative Commons Attribution 4.0 license. Any further distribution of this work must maintain attribution to the author(s) and the title of the work, journal citation and DOI.
1. Introduction
Inappropriate and overuse of broad-spectrum antibiotics has led to a drastic increase in antibiotic resistance. Experts have declared it a global health emergency, as many infections such as ear, and urinary tract infections, sexually transmitted infections such as gonorrhoea, pneumonia, tuberculosis, and wound infections are caused by microorganisms that are resistant to one or more antibiotics [1]. A recent study published in The Lancet presented the most comprehensive burden of antimicrobial resistance (AMR). According to the study, an estimated 4.95 million deaths were associated with bacterial AMR in 2019. Antimicrobial resistant microorganisms associated with deaths included Escherichia coli, Staphylococcus aureus, Klebsiella pneumoniae, Streptococcus pneumoniae, Acinetobacter baumannii, and Pseudomonas aeruginosa. These pathogens were responsible for 929 000 deaths, with methicillin-resistant S. aureus responsible for more than 100 000 of these in 2019 [2]. Although several new antibiotics have been developed over the past few decades, none of these has exhibited improved antimicrobial activity against multidrug-resistant bacteria [3]. Thus, the emergence of multidrug-resistant strains and the associated healthcare costs highlight the need to develop novel and effective alternative antimicrobial strategies to combat infectious diseases and minimise resistance. Microorganisms rapidly adapt to the changing environment and rapidly become resistant to antimicrobials, particularly those with a specific mode of action, such as antibiotics. Therefore, novel antimicrobials that are not only effective but also non-specific in their mode of action are a potential way forward.
Metals have long been used as antimicrobials; for example, copper plates were used to sterilise drinking water and, recently, coat door handles [4]. Silver has also been widely used in recent times in several fields, such as dental implants, catheters and burn wounds [5, 6]. With the advent of nanotechnology, metal nanoparticles have become the latest research focus. Although metallic nanoparticles can be inert in nature, it is believed that following immersion in an aqueous solution, free metal ions and reactive oxygen species (ROS) generated on the particle surface exert antimicrobial effects [7]. Nanoparticles can kill bacterial cells non-specifically by targeting multiple components. The antimicrobial activity of nanoparticles is mainly dependent on particle size; in general the size of bacterial cells is in the micrometre range while the pores in the cell membrane are of nanometre range. Therefore, nanoparticle activity is not merely due to the release of free metal ions but also a high surface area to volume ratio, allowing nanoparticles to interact closely with microbial membranes. Furthermore, the relatively non-specific mode of action of metal nanoparticles reduces the rate at which resistance is developed, making them attractive prospects as alternative antimicrobials.
Metal and metal oxide based nanoparticles have been widely studied for their antimicrobial efficacy against a range of bacterial strains. For instance, silver nanoparticles have gained particular attention due to their application as antimicrobial coating for devices [8]. Similarly, gold, gallium, zinc oxide and magnesium oxide nanoparticles have shown promising antimicrobial effects [9]. In addition, combining two antibiotics or antimicrobials to enhance their efficacy in a synergistic approach has been widely researched, as this potentially offers several benefits over monotherapy [10–14]. For instance, it broadens the antimicrobial spectrum and targets polymicrobial infections effectively. Furthermore, combination therapy lowers the chances of resistance emergence and the time and concentrations required to kill pathogens, thus likely to reduce the host cell toxicity. This study aimed to investigate the antimicrobial efficacy of pure metal nanoparticles and whether combination of these nanoparticles results in synergistic enhancement of antimicrobial activity against clinically relevant microorganisms.
2. Methods and materials
2.1. Nanoparticles
Nanoparticles used in the investigation, silver (Ag), cobalt (Co), copper (Cu) and zinc (Zn), were purchased from Nanostructured and Amorphous Materials Inc. USA. Cu, Ag and Zn nanoparticles were in the metallic form; however, Co nanoparticles were partially passivated with oxygen (∼10%). Physical properties of the nanoparticles are shown in table 1. The size of the cobalt nanoparticles was smaller than the other metals used due to the lack of availability of similar sizes at the time study was undertaken. According to the manufacturer, Co and Zn nanoparticles were synthesised using the plasma chemical vapour deposition method, whereas Ag and Cu were prepared using chemical methods. All nanoparticles were characterised using transmission electron microscopy and the purity was quantified using inductively coupled plasma emission spectroscopy. Prior to conducting assays, the nanoparticles were sterilised by exposing them to UVB radiation for 15 min.
Table 1. Physical characteristics of the nanoparticles.
| Nanoparticle | Purity | Size | Shape |
|---|---|---|---|
| Silver | 99.9% | 80 nm | Spherical |
| Cobalt | 99.8% | 28 nm | Spherical |
| Copper | 99.9% | 50–80 nm | Spherical |
| Zinc | 99.5% | 80 nm | Spherical |
2.2. Microorganisms
The antimicrobial efficacy of the nanoparticles was assessed against standard type-culture strains; E. coli (NCTC 10538) and S. aureus (ATCC 6538). In addition, three clinical isolates of Escherichia coli (Strains 1, 2 and 3) and S.epidermidis (A37, A57 and A91) recovered from patients with cystitis and bone-marrow transplant patients, respectively, were used in the preliminary agar diffusion assays. All isolates for all assays were grown overnight in nutrient broth (Oxoid Ltd, UK) at 37 °C in an aerobic environment. Clinical isolates were obtained from frozen stock cultures maintained at the Queen Elizabeth Hospital, Birmingham, UK.
2.3. Determination of antimicrobial activity of metal nanoparticles and antibiotics using agar diffusion assay
The antimicrobial efficacy of metal nanoparticles against laboratory and clinical isolates was assessed in accordance with EUCAST guidelines. Iso-Sensitest agar (Oxoid Ltd, UK) plates were inoculated with approximately 1 × 105 CFU ml−1. Plates were kept at room temperature for 10 min to allow bacterial adsorption. Using a sterile glass Pasteur pipette, 6 mm wells were punched in the agar. The bottom of the well was sealed by adding 20 µl of molten agar. Nanoparticles suspensions at 10% w/v (100 mg ml−1) and 20% w/v (200 mg ml−1) were prepared and 50 µl was added into the respective wells along with negative (phosphate buffer saline—PBS) controls. The plates were incubated overnight in an aerobic environment at 37 °C, and zones of inhibition were determined by measuring the diameter of the clear zone by holding a metric ruler against the back of the Petri dish. Antibiogram profiles and zones of inhibition were determined for all microorganisms using the same protocols as above against trimethoprim (2.5 µg), ampicillin (10 µg), ciprofloxacin (1 µg) and gentamicin (10 µg).
2.4. Determination of minimum inhibitory concentration (MIC) and minimum bactericidal concentration (MBC)
Broth macrodilution was performed in accordance with CLSI guidelines [15] to determine the MIC and MBC of the nanoparticles against standard laboratory isolates (E. coli NCTC 10538 and S. aureus ATCC 6538). Double dilutions of each nanoparticle were performed from 0.02 to 5.0 mg ml−1 by adding 1 ml sterile PBS and 1 ml Mueller Hinton broth (Oxoid Ltd, UK.) to 10 mg of nanoparticles, followed by subsequent dilution. To maintain equal volumes throughout the procedure, 1 ml of the solution was discarded from the last dilution. Samples were then inoculated with 1 × 105 CFU ml−1 and incubated overnight in a shaking incubator at 200 rpm at 37 °C. Solution devoid of nanoparticles, under the same growth condition, was used as a control. To avoid potential misinterpretation of turbidity due to coloured colloidal suspension of nanoparticles, the same liquid medium without microorganisms but containing the same concentration of nanoparticles was used as standard solutions for comparison. Following overnight incubation, the optical density of the test solutions was measured and normalised against nanoparticles standard solutions to determine MICs.
A 100 µl volume of the lowest concentration that was not visually turbid was streaked onto Mueller Hinton agar and incubated overnight at 37 °C in an aerobic chamber. MBCs were determined by performing serial dilutions of the test samples in D/E neutraliser (Fisher Scientific, UK) and plated on to nutrient agar plates. Following overnight incubation at 37 °C in an aerobic chamber, viable counts were determined. Tests were repeated three times. MIC was determined as the lowest concentration of nanoparticle suspension, which showed no turbidity on visual inspection but yielded bacterial growth when incubated on Mueller–Hinton agar. Whereas MBC was determined as the lowest concentration of nanoparticle suspension, which yielded three log reductions (99.9%) on spread plates.
2.5. Time-kill and synergy assay
The time-kill of the nanoparticles alone and in combination, along with synergy determination was assessed using a suspension method time-kill assay as described by White et al [16]. Three experimental suspensions were prepared at twice the MIC concentration for each combination: metal A only suspension, metal B only suspension and a combination A + B suspension. All experimental tubes, each metal alone and in combination (Co + Cu, Co + Zn, Co + Ag, Cu + Zn, Cu + Ag and Ag + Zn) were seeded with an initial microbial density of 105 CFU ml−1. In addition, a positive control containing Mueller–Hinton broth seeded with a microbial inoculum only and negative control containing broth only, were prepared. All tubes were incubated aerobically at 37 °C in a shaking incubator (200 rpm). At time periods 0, 2, 6 and 24 h, 100 µl aliquots were diluted 1:10 in D/E neutralization buffer to prevent antimicrobial carry-over. Diluted samples were sub-cultured on Mueller–Hinton agar and incubated at 37 °C for 24 h under aerobic conditions, after which CFUs were determined. The significance of the results was determined using Tukey's multiple comparison tests of repeated measures ANOVA.
3. Results and discussion
3.1. Antimicrobial activity of nanoparticles as determined by agar-diffusion assay
Figure 1 shows the diameter of zones of inhibition recorded for 10% and 20% w/v suspension of copper, cobalt, silver and zinc against laboratory (S. aureus ATCC 6538 and E. coli NCTC 10538) and clinical isolates of S. epidermidis (A37, A57, A91) and E. coli (strains 1, 2 and 3). Overall, the data showed statistically significant antimicrobial efficacy of copper and cobalt (p < 0.001) nanoparticles against both strains when compared to zinc and silver, where the zones of inhibition were smaller (figure 1(A)). The enhanced effect of copper and cobalt is likely due to the nanoparticles' smaller size than silver and zinc nanoparticles.
Figure 1. Shows mean diameter of zones of inhibition recorded for metallic nanoparticles against a panel of microorganisms ((A)–(E). coli, (B)–(S). aureus): copper and cobalt inhibition was observed against all stains. Strong activity was seen by copper against all strains, particularly maximum activity was observed against A91. Zinc and silver showed moderate to weak activity. Data shows mean of three replicates ±SD.
Download figure:
Standard image High-resolution imageCopper nanoparticles exhibited the strongest antimicrobial effect against all strains, with the largest zone of inhibition produced against A91 (25.16 mm ± 2.88) (figure 1(B)). Except for S. epidermidis A91, copper demonstrated greater antimicrobial efficacy against E. coli (Gram-negative) than S. aureus (Gram-positive). These data concur with findings of other growth inhibition studies, which show that strains of E. coli are generally more susceptible to copper nanoparticles than S. aureus [17]. While the exact mechanism of action of metallic copper is yet to be identified, contact-mediated killing initiating membrane degradation is a widely accepted mechanism [18]. The reduced susceptibility of Gram-positive strains to copper is likely, due to the thick peptidoglycan layer. Gram-negative bacteria consist of a thin layer of peptidoglycan (8 nm), whereas the peptidoglycan layer measures 80 nm in Gram-positive bacteria, reducing the cell wall permeability of metal ions [19].
Surprisingly, silver nanoparticles exhibited the lowest level of antimicrobial activity with no zones of inhibition produced by the 10% silver nanoparticles against any of the strains of E. coli, while 20% silver nanoparticles had small zones of inhibition against E. coli strain 1–3. The largest average zone of inhibition produced by 20% silver was against S. epidermidis A37 (11.6 ± 0.5 mm). While silver has been successfully used for various biomedical applications [20, 21] recently, bacterial resistance to silver has been reported [22]. However, the authors hypothesised the resistance evolved without genetic changes and was due to the adhesive flagellum protein flagellin's production, which triggers the nanoparticles' aggregation [22].
Antibiogram profiles of all test isolates were generated (figure 2) against a panel of antibiotics commonly used in general practice and the nosocomial settings (10 µg ampicillin, 10 µg gentamicin, 1 µg ciprofloxacin and 2.5 µg trimethoprim). Most bacterial strains were shown to be sensitive to the majority of antibiotics in the panel, with the exception of S. epidermidis A91 (resistant to gentamicin, ciprofloxacin and trimethoprim) and E. coli strain 1 and 2 (resistant to ampicillin and trimethoprim). All microorganisms, including those shown to be resistant to one or more antibiotics, displayed sensitivity to copper, cobalt, and zinc nanoparticles. One of the most striking aspects of the results is a high growth inhibition of S. epidermidis A91. In this current study, the strain displayed sensitivity to copper, cobalt and zinc nanoparticles despite complete resistance to ciprofloxacin and trimethoprim (figure 3).
Figure 2. Antibiogram of the standard and clinical isolates against a panel of antibiotics (1 µg ciprofloxacin, 2.5 µg trimethoprim, 10 µg gentamicin and 10 µg ampicillin). Zones of inhibition are seen with all antibiotics in control strains but not in clinical isolates.
Download figure:
Standard image High-resolution imageFigure 3. Staphylococcus epidermidis A91 growth inhibition by the disk diffusion method. 1 µg ciprofloxacin (A, E, J), PBS (B, F), 10% Co (C), 20% Co (D) 10% Cu (G) and 20% Cu nanoparticle solutions (H) on Iso-Sensitest agar. Ciprofloxacin (J) and trimethoprim (K) showed no activity against this strain. Gentamicin (L) shows only a small zone of inhibition (14 ± 2 mm) whereas ampicillin shows a relatively large zone (28 ± 3 mm) (I).
Download figure:
Standard image High-resolution imageThe complete resistance to trimethoprim displayed by all clinical isolates of E. coli is not entirely surprising as the vast majority of urinary tract infections are caused by E. coli species and trimethoprim is a broad-spectrum antibiotic often used as first-line treatment for cystitis. The widespread use of trimethoprim without urine sample culturing and sensitivity profiling of pathogens prior to administration of the antibiotic has led to an emergence of trimethoprim resistant urinary pathogenic E. coli (figure 4). On the contrary, single resistant colonies were not observed in nanoparticles treated groups. The relatively non-specific actions of metal nanoparticle toxicity reduce the chance of resistance developing within microbial populations and may potentially allow for the successful treatment of antibiotic resistant infections; indeed, we have demonstrated sensitivity using 10% and 20% cobalt and copper nanoparticles against this strain of E. coli.
Figure 4. E. coli clinical isolate strain 3 growth inhibition by the disk diffusion method. 2.5 µg trimethoprim (A), (E), (K), PBS (B), (F), 10% Cu (C), 20% Cu (D) 10% Zn (G) and 20% Zn nanoparticle solutions (H), ampicillin (I), ciprofloxacin (J) and gentamicin (L) on Iso-Sensitest agar. E. coli strain 3 shows complete resistance to trimethoprim and multiple morphologically identical, resistant colonies are seen within the clear zones of inhibition for ciprofloxacin and gentamicin (marked by arrows).
Download figure:
Standard image High-resolution image3.2. Determination of MIC and MBC
The MICs and MBCs represent the antimicrobial efficacy of nanoparticles against type culture microorganisms; S. aureus ATCC 6538 and E. coli NCTC 10538 and are illustrated in table 2. In suspension analysis, zinc and silver demonstrated higher antibacterial activity than the copper and cobalt nanoparticles. While E. coli and S. aureus demonstrated similar sensitivity patterns against copper and cobalt nanoparticles, a higher sensitivity was observed by S. aureus against zinc and silver compared to E. coli. With the exception of cobalt, E. coli exhibited identical MICs for copper, zinc and silver nanoparticles, whereas S. aureus showed higher MIC for copper compared to silver and zinc, suggesting higher efficacy of zinc and silver and strain specificity.
Table 2. Minimum inhibitory concentrations (MICs) and bactericidal concentrations (MBCs) (mg ml−1) of Cu, Co, Zn and Ag nanoparticles against control strains S. aureus ATCC 6538 and E. coli NCTC 10 538. Broth macrodilution was performed in line with CLSI guidelines to generate MIC/MBC data.
| S. aureus ATCC 6538 | E. coli NCTC 10538 | |||
|---|---|---|---|---|
| MIC (mg ml−1) | MBC (mg ml−1) | MIC (mg ml−1) | MBC (mg ml−1) | |
| Copper | 1.25 | 2.50 | 1.25 | 2.50 |
| Cobalt | 5.00 | >5.00 | 5.00 | >5.00 |
| Zinc | 0.625 | 1.25 | 1.25 | 2.50 |
| Silver | 0.625 | 1.25 | 1.25 | 5.00 |
The MIC values in the present analysis are much higher than those reported previously; for example, Ruparelia et al [23] on silver and copper nanoparticles against S. aureus and E. coli reported very low MIC values, 40–280 µg ml−1. However, Ren et al [24] reported higher MIC/MBC, 100–5000 µg ml−1, than Ruparelia and co-workers. Several factors such as size and shape, agglomeration and passivation of nanoparticles determine the activity of nanoparticles. In general, the antimicrobial efficacy increases with the increase in surface area to volume ratio due to decreased particle size. Thus, a direct comparison with other studies is difficult due to the variation in the size of nanoparticles used in different studies.
The much lower MIC values of silver and zinc against S. aureus compared to E. coli support the data published by Ruparelia et al [23] as well as Parit et al [25], which demonstrated that E. coli strains are more resistant than S. aureus. It is generally speculated that the difference in the cell wall structure of microorganisms plays a crucial role in the different efficacy of the antimicrobials. Gram-positive cell walls, due to thick peptidoglycan, are believed to confer resistance to contact-mediated killing. Furthermore, Gram-negative cell walls are generally more anionic due to the abundance of lipopolysaccharides; therefore, they have a differential permeability for ROS [26], making Gram-negative more susceptible. However, the antimicrobial activity of nanoparticles is not solely dependent on the structure of the bacterial cell wall, as there are multiple target sites such as mitochondria, cytosol proteins and DNA within the bacterial cells; therefore, conflicting data have been reported.
3.3. Time kill assay and determination of potential synergistic antimicrobial activity of metal nanoparticles
Time kill assay was used to evaluate the antimicrobial effect of nanoparticles over 24 h and to assess whether a two-metal nanoparticle combination can work simultaneously to give additive or synergistic effect. For the given assay, the synergistic effect was evaluated at twice the MIC concentration and the resulting ratio of each nanoparticle in a given combination are illustrated in table 3.
Table 3. Ratio of individual nanoparticles in the studied combinations.
| S. aureus ATCC 6538 | E. coli NCTC 10538 | |
|---|---|---|
| Cu + Co | 1:4 | 1:4 |
| Co + Zn | 8:1 | 4:1 |
| Co + Ag | 8:1 | 4:1 |
| Cu + Zn | 2:1 | 1:1 |
| CU + Ag | 2:1 | 1:1 |
| Ag + Zn | 1:1 | 1:1 |
Samples were seeded with 105 CFU ml−1 of microbial inoculum and incubated at 37 °C. In control samples, devoid of nanoparticles, the bacterial density increased to 109 CFU ml−1 over 24 h of incubation. All metal nanoparticles and their combinations showed potent antimicrobial activity against both strains except cobalt nanoparticles. From figures 5 and 6, it is seen that the bacterial load decreased significantly within two hours (p ⩽ 0.001) for copper, zinc and silver and the significance further increased within 6 h of incubation (p ⩽ 0.0001). However, cobalt failed to demonstrate antimicrobial activity even at 24 h as no significant difference was observed compared to control. Furthermore, the antimicrobial effect was strain specific, where E. coli showed more susceptibility than S. aureus.
Figure 5. Time kill curve of S. aureus ATCC 6538 treated with pure metals; alone and in combination at 2xMIC in Muller Hinton broth incubated at 37 °C/200 rpm. Samples were taken at 2, 6 and 24 h. Bacterial viability is presented as log CFU ml–1. Data shown are expressed as mean ± SD (N = 3).
Download figure:
Standard image High-resolution imageFigure 6. Time kill curve of E. coli NCTC 10 538 treated with pure metals; alone and in combination at 2xMIC in Muller Hinton broth incubated at 37 °C/200 rpm. Samples were taken at 2, 6 and 24 h and log CFU ml–1 was determined. A significant reduction (p ⩽ 0.001) in bacterial load was observed within 6 h and complete kill within 24 h for all metals except for cobalt.
Download figure:
Standard image High-resolution imageInterestingly, various combinations showed an enhanced activity at 6 h compared to the individual agents. For instance, at 2 h the combination of copper and silver nanoparticles reduced bacterial load by two logs compared to one log reduction by copper and silver alone against S. aureus and E. coli. The difference was further evident at 6 h, where the combined metals resulted in complete bacterial kill (5 log reduction; 99.999%) compared to individual nanoparticles; copper (2 log reduction) and silver (1 log reduction). A similar effect was observed for cobalt and silver against E. coli where at the 6-hour time point, a complete kill (5 log reduction; 99.999%) was observed as opposed to 1 log reduction for silver and no effect, i.e. zero long reduction for cobalt. Likewise while zinc only showed less than 2 log reduction and no activity was seen for cobalt, a synergistic effect was seen at 24 h when both metals were combined. The data also shows that the time required to achieve complete kill is substantially reduced when antimicrobials are tested in combinations. When tested alone, copper and silver showed a complete kill against both strains; however, the complete eradication was achieved within 6 h when both metals were combined. This shows that not only two antimicrobials can act synergistically but also the time required to achieve the desired effect can be greatly reduced.
Our data demonstrated an enhanced antimicrobial effect of metal nanoparticles when combined. Metals have been widely investigated for their broad antimicrobial potential primarily via the production of ROS and cell membrane damage [7]. Nevertheless, while metals have non-specific action, they can target specific cellular components and, therefore, are likely to enhance pathogen clearance when combined. Silver ions have been reported to initiate cell death through association with disulphide bonds in enzymes, thus interfering with normal metabolic processes [27]. Furthermore, silver binds with phosphorus in bacterial DNA, thus impairing DNA replication and protein expression [28]. Copper, on the other hand, can not only disrupt DNA and cell membrane by ROS production but also alter metabolic pathways [17, 29] Cobalt has been shown to disrupt iron homeostasis through interaction with Fe–S clusters which are critical co-factors for respiration and DNA repair [30]. While the mode of action of some metal ions has been extensively studied, to the authors' knowledge, the combined mode of action has yet to be researched. A varied chemical reactivity of metal ions with bacterial cells and their unique cellular targets explains the difference in the antimicrobial efficacy between different combinations.
The most unusual finding of the given investigation is the lack of antimicrobial activity of cobalt nanoparticles in suspension analysis. Unlike the other nanoparticles used in this study, the cobalt nanoparticles were partially passivated at the time of manufacture to avoid surface oxidation. Therefore, the activity loss could be partially due to the protective coating on the cobalt nanoparticles. Even though there is a lack of data showing the antimicrobial properties of cobalt or cobalt oxide nanoparticles, metallic cobalt has been shown to demonstrate antimicrobial action against S. aureus and E. coli [31, 32]. With the exception of cobalt and zinc, all nanoparticles and their combinations showed a rapid and effective antimicrobial activity. Despite the rapid actions of treatment groups, no significant difference was seen between copper and Cu + Co or silver and Ag + Co after 24 h, indicating no synergistic or antagonistic effects of the combination metals. The lack of antimicrobial activity exhibited by cobalt treatment groups and lack of significance between copper and Cu + Co or silver and Ag + Co groups suggests that the reduction in bacterial load seen in Cu + Co and Ag + Co treatment groups is attributable to the actions of copper and silver alone.
In contrast to solid-phase analysis, the agar diffusion assay, silver exhibited effective antimicrobial activity in suspension analysis. One of the reasons for the variable activity could be physical characteristics of the nanoparticles. It is well established that the size and shape of the antimicrobial affects the size of the zone of inhibition. The silver nanoparticles used investigated in the given study were slightly bigger than the other nanoparticles, suggesting that the silver nanoparticles diffused less easily through agar. Thus, minimal or no zones of inhibition were observed. In addition, when in suspension, the effect of nanoparticles is exerted in two ways: direct contact and indirect by the release of free metal ions in the suspension. Nanoparticles are believed to rupture the outer cell wall, allowing free metal ions to enter the cell, causing protein denaturation and cell death [33]. Therefore, to inhibit or kill microorganisms, the size of silver nanoparticles should be very small, as demonstrated by or in an aqueous environment [34–36].
4. Conclusion
In this study, a significant antimicrobial efficacy of metal nanoparticles, alone and in combination was demonstrated against both gram-positive and gram-negative bacteria. When combined metal nanoparticles, cobalt, silver and zinc combinations (Co + Zn, Co + Ag, Ag + Zn) showed synergistic effect against both strains. On the other hand, no synergistic effect was seen for copper combinations due to strong antimicrobial activity of copper alone, nevertheless copper when combined with other metals such as silver reduced the time required to achieve complete kill to 6 h. This study also highlights the prevalence of multidrug-resistant strains within the clinical setting and the significance of using metal nanoparticles as alternative antimicrobials to eliminate microorganisms including those resistant to antibiotics. However, prior to using metal nanoparticles for in vivo application, toxicity to mammalian cells must be considered and further work undertaken. While copper, cobalt and zinc are essential minerals for several biological functions, however just like bacterial metal ions, homeostatic mechanisms can become saturated, and mammalian cells can also be overwhelmed, thus leading to cytotoxicity. Further studies such as time-kill assays at lower concentrations and cell studies are required to determine therapeutic window before the use in vivo.
Acknowledgments
The authors gratefully acknowledge the Aston Research Centre for Healthy Ageing (ARCHA) and Insight health Ltd for providing funds to conduct this study. The authors would also like to thank Aimee Guiste, Daniel Marshall and Ilona Vitkauskaite for their support in the laboratory.
Data availability statement
The data cannot be made publicly available upon publication because they are not available in a format that is sufficiently accessible or reusable by other researchers. The data that support the findings of this study are available upon reasonable request from the authors.
Conflict of interest
The authors declare no competing interests.
Funding
Funded by: Aston University and Insight Health Ltd, Wembley, London.